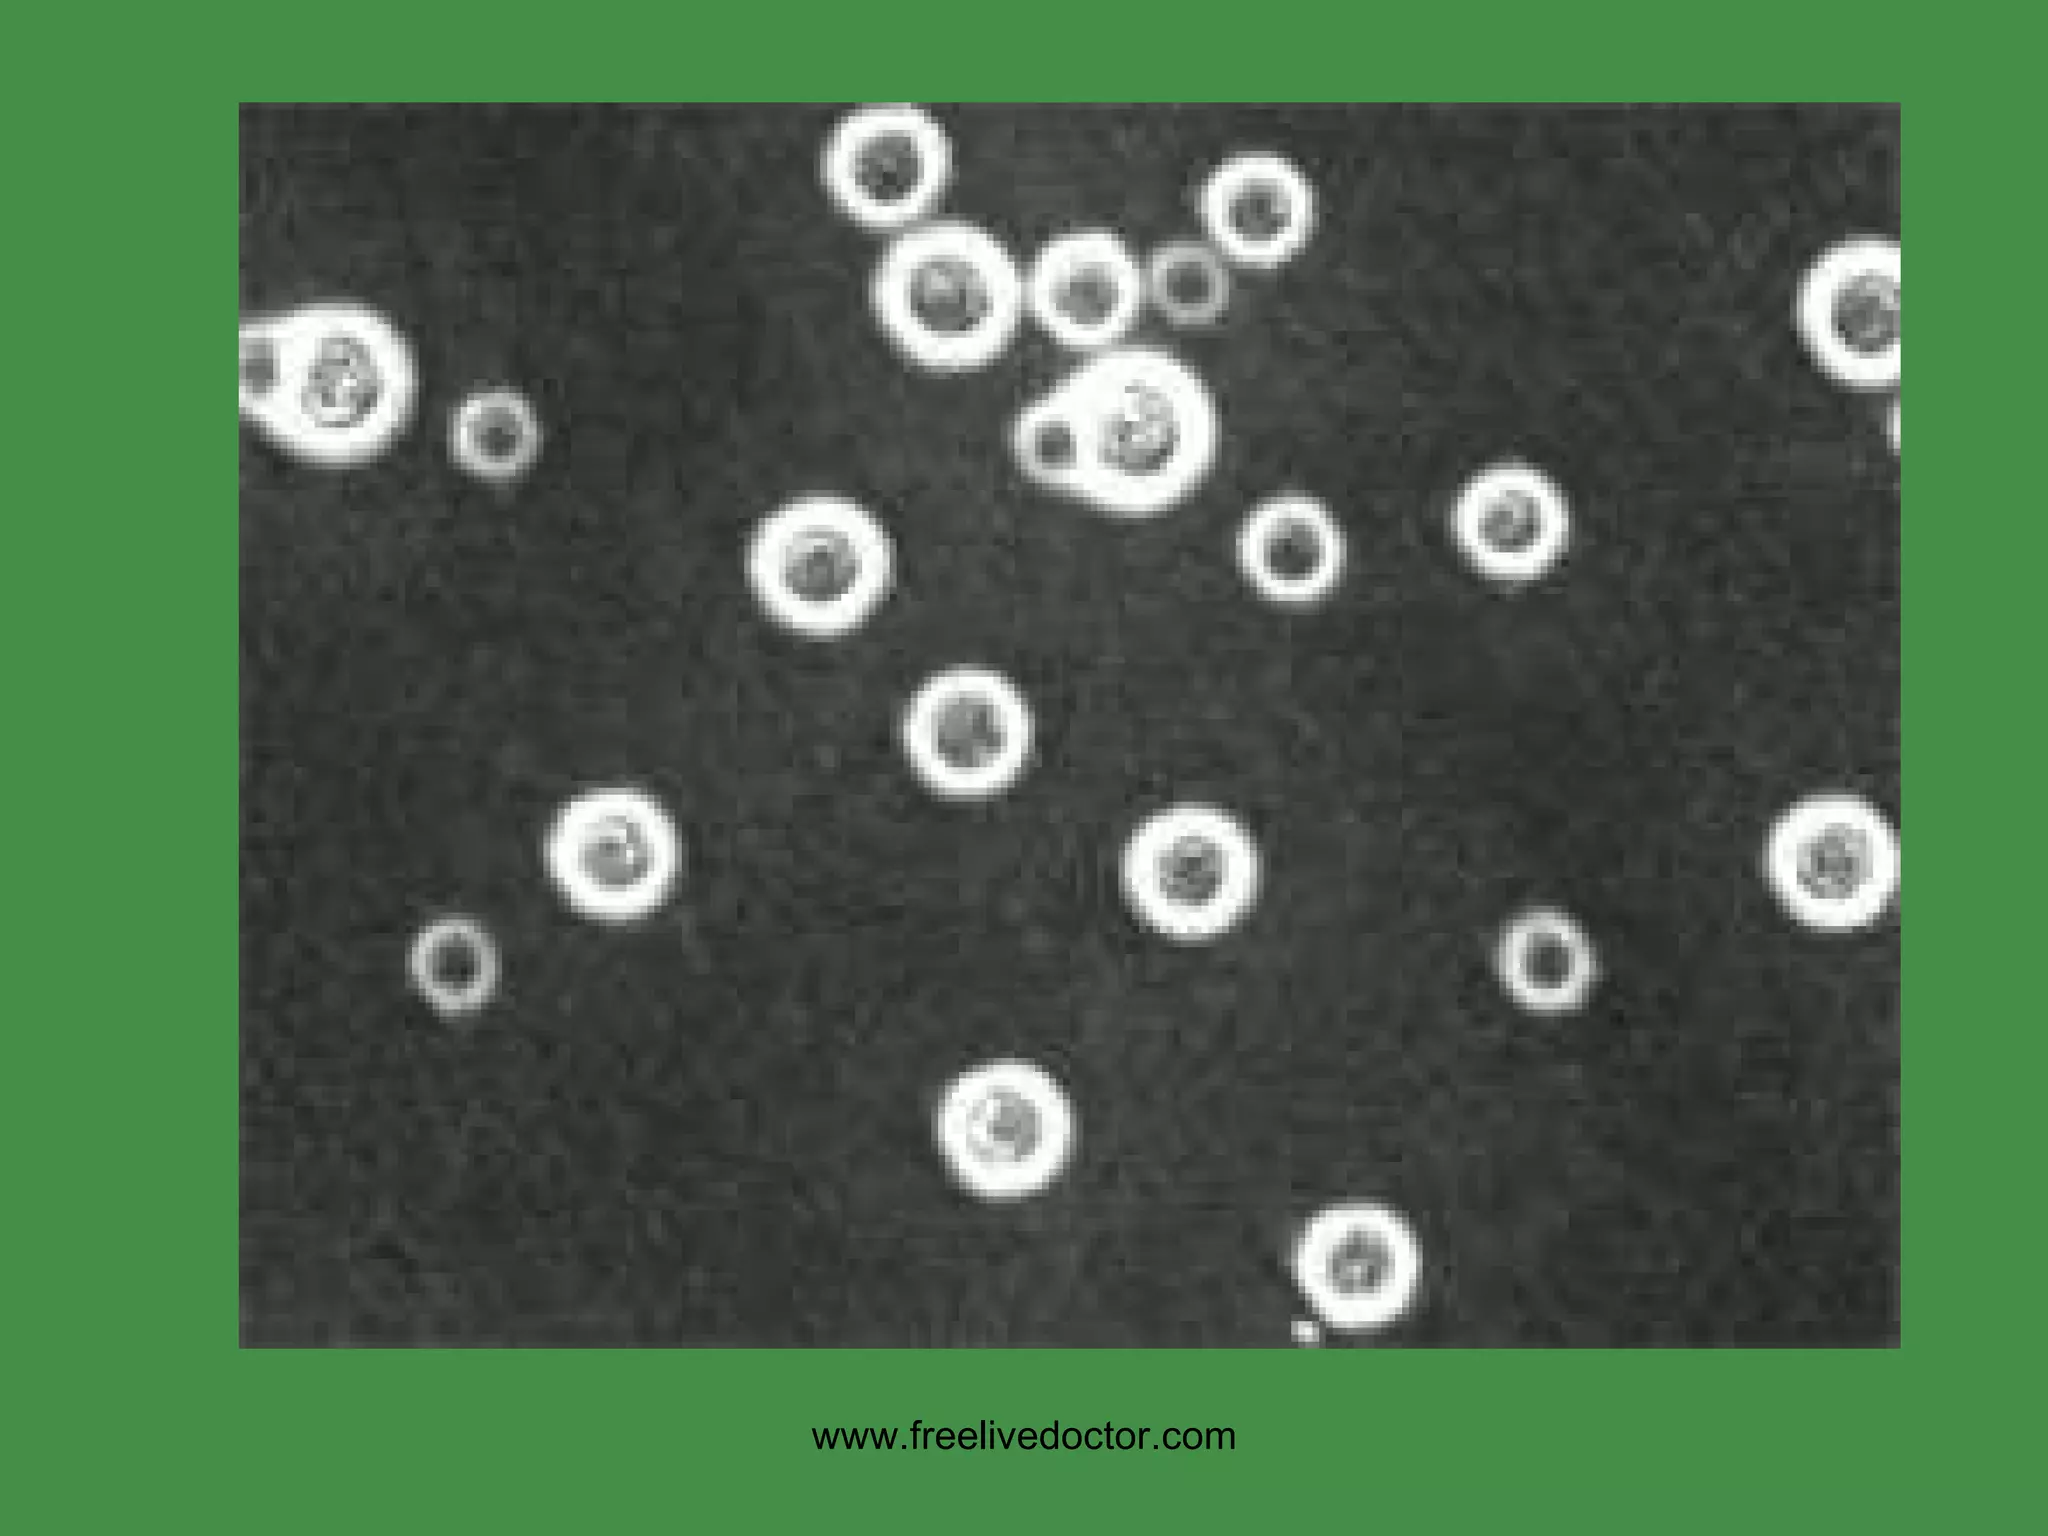
www.freelivedoctor.com

The document provides an overview of various cellular reactions, disease patterns, malformations, injuries, and degenerative conditions that can affect the central nervous system (CNS). It discusses the different cell types of the CNS, including neurons, glia and their roles. Common CNS disease patterns are described as degenerative, inflammatory, neoplastic and traumatic. Specific CNS diseases, injuries, infections, malformations and degenerative conditions are then outlined in detail with their characteristic clinical and pathological features.